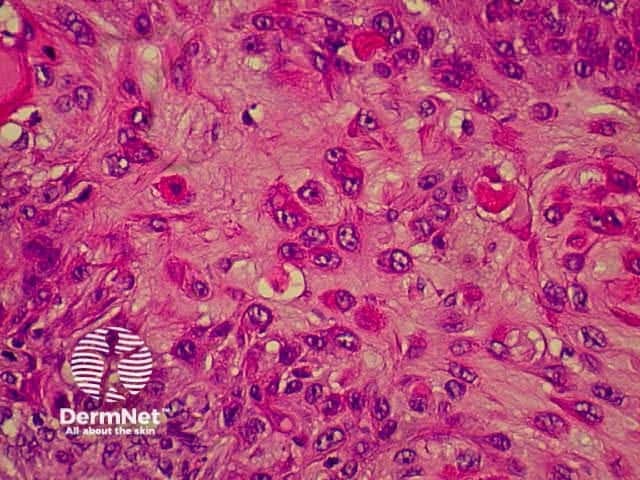
Pathology of SCC
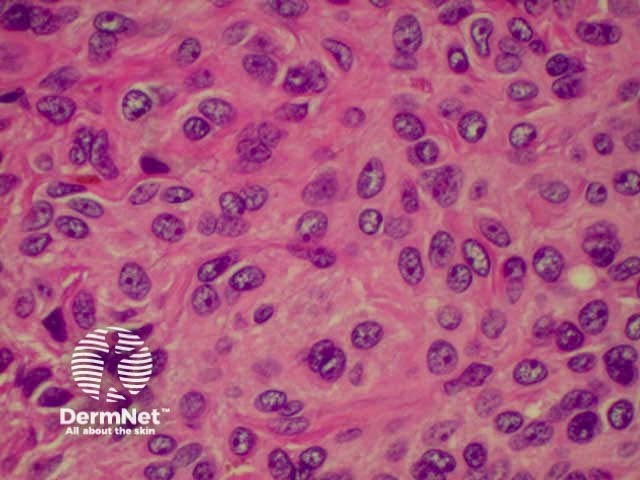
Superficial naevus cells
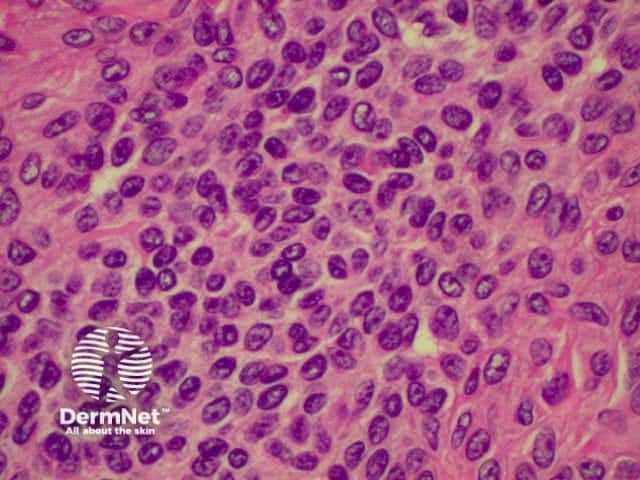
Deep naevus cells
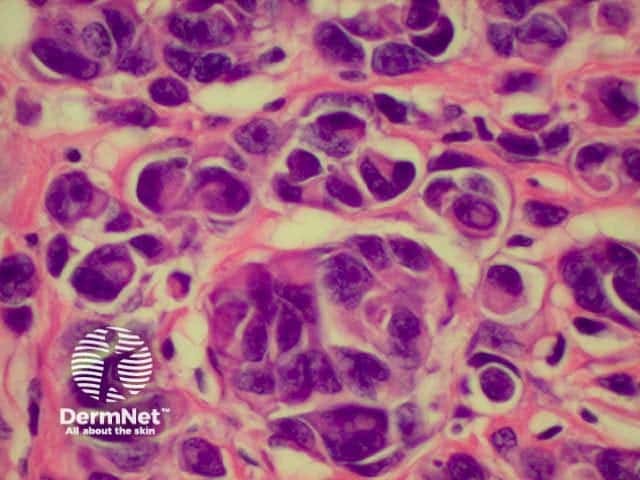
High power view
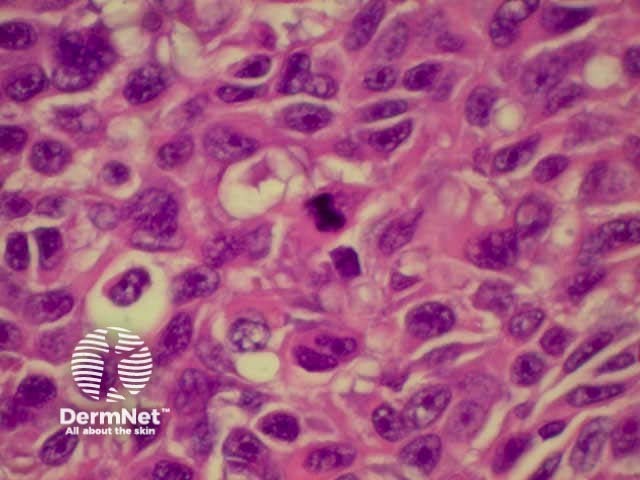
Pathology of Superficial spreading melanoma
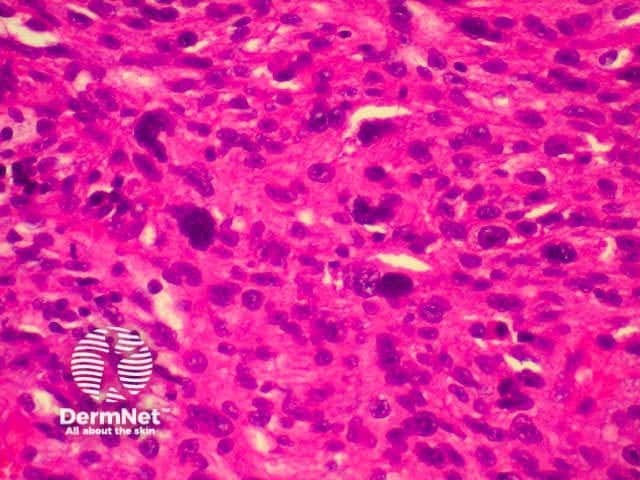
pathology of atypical fibroxanthoma

Main menu
Common skin conditions

NEWS
Join DermNet PRO
Read more
Quick links
Created 2008.
The identification of many skin tumours is fairly straightforward, but the diagnosis of some tumours (particularly some melanocytic tumours) can be very difficult. Tumours do not always have textbook appearances. On occasions even experts disagree as to whether a melanocytic lesion is benign or malignant. Sometimes malignant lesions show no obvious histological features to suggest their cell type i.e. they become anaplastic. Special stains especially immunoperoxidase stains can be useful in such cases.
The pathology of the following skin tumours will be outlined:
Descriptions refer to routine sections stained with haematoxylin and eosin (H&E).
| Basaloid tumour cells | The cells resemble cells from the basal epidermal layer i.e. have a dark oval nucleus and little cytoplasm |
| Epithelioid cells | Cells resemble epithelial cells in having ample pale cytoplasm and pale vesicular nuclei. They may be tumour cells or macrophages |
| Foam cells | Cells with bubbly cytoplasm (usually macrophages) |
| Spindle cells | Long thin cells of many cell types |
| Squamous eddies, horn pearls and horn cyst | Concentric whorled arrangement of keratinocytes, more keratinised in the middle (marked keratinisation is called a horn pearl or horn cyst) |
| Epidermotropism | The migration of malignant cells into the epidermis (usually refers to lymphocytes) |
| Pagetoid spread | Individual cell spread of malignant cells in the epidermis in a ‘buckshot’ pattern |
| Pautrier Microabscesses | Clusters of atypical lymphocytes in the epidermis with little associated spongiosis. |
Among other names, the seborrhoeic keratosis is sometimes reported as basal cell papilloma, i.e. a benign neoplasm of basal cells. Link ta clinical description of seborrhoeic keratosis.
The histological features of seborrhoeic keratoses may be quite varied and can overlap with solar lentigo, but typically show:
Basal call carcinomas (BCC) have a variety of histological subtypes. Link ta clinical description of basal cell carcinoma.
Various descriptive terms may be used, but there are four main types (more than one pattern may be present in any one tumour).
| Nodular BCC | A well demarcated tumour without significant infiltration in surrounding tissue. |
| Superficial BCC | A poorly demarcated tumour that histologically is composed of small isolated islands of tumour attached to the base of the epidermis. In reality these are probably all connected, but the connections cannot be seen in the two-dimensional section therefore assessment of the margins of these tumours is difficult. |
| Infiltrative BCC | These lesions are composed of small islands of tumour cells which do not form a cohesive mass, but which diffusely infiltrate in the dermis and subcutis. The margins are difficult to define clinically and sometimes histologically. These tumours are therefore often incompletely excised initially. They have a tendency to recur aggressively if not completely removed. They may also show perineural invasion, and if so, the margin of clearance needs to be wider still as there is even more risk of aggressive behaviour. If these tumours are accompanied by stromal fibrosis, they may be referred to as ‘morphoeic’. |
| Micronodular BCC | These lesions are composed of small islands of tumour cells which are diffusely scattered in the dermis rather than circumscribed as are nodular tumours. They are prone to local recurrence if not excised with a satisfactory margin, and they may show perineural invasion, but are not as aggressive as infiltrative tumours. |
The histological features of basal cell carcinoma are typically:
Pathology of BCC Pathology of BCC 

The solar or actinic keratosis is a small scaly spot arising in sun-exposed skin. It is a very superficial and non-invasive. Link ta clinical description of actinic keratosis.
The histological features of actinic keratoses are:
Pathology of actinic keratosis Close-up 

Superficial, intraepidermal or in-situ squamous cell carcinoma is also described clinically as Bowen disease and presents as a slowly growing red scaly or crusted plaque. It may arise in non-sun exposed skin as well as in sun-exposed skin. Link to a clinical description of in situ squamous cell carcinoma.
The histological features of in-situ squamous cell carcinoma show extensive overlap with actinic keratosis and are:
Pathology of in situ SCC 
Invasive squamous cell carcinoma (SCC) is characterised by dermal invasion. Link to a clinical description of invasive squamous cell carcinoma.
SCC is characterised by proliferation of irregular nests of abnormal squamous cells arising from the epidermis and invading the dermis. Tumours are traditionally divided into well, moderately or poorly differentiated tumours by a subjective assessment of how significantly the tumour cells differ from normal keratinocytes. In general, the greater the degree of keratinization, the better differentiated the tumour is thought to be. Except in the case of very poorly differentiated tumours, this does not have a great bearing on prognosis. More important is the depth and irregularity of invasion, particularly the presence of perineural infiltration, which is associated with a much higher rate of recurrence if not widely excised. The site of the lesion is also important; tumours of the lips and ears have a considerably higher rate of metastasis to lymph nodes.
There are several descriptive variants of SCC including spindle cell SCC and acantholytic (or adenoid or pseudoglandular SCC). These mainly are of note due to the difficulty of diagnosing the tumour as SCC, but they may also imply a slightly worse prognosis. A further rare variant is verrucous carcinoma, a lesion in which the histology has a deceptively benign appearance in that there is very little cytological abnormality. Diagnosis in these cases may be delayed and the diagnosis may not be made until several biopsies have been performed. These tumours recur locally, but do not generally metastasise.
From the above comments it can be seen that the histological features of SCCs can vary, but in general are:
Pathology of SCC Pathology of SCC Pathology of SCC Pathology of SCC

A cyst is a walled-off cavity filled with keratin, mucin or fluid. Cysts may become acutely inflamed, in which case there is a marked neutrophil infiltrate, or rupture can result in a surrounding granulomatous infiltrate.Link ta clinical description of cysts.
The histological features of epidermal inclusion cysts (epidermoid cysts) are:
Pilar cysts, which are typical of scalp ‘sebaceous cysts’, show:
Pathology of pilar cyst 
A lentigo is a flat brown patch (freckle). Strictly, a lentigo shows increased basal melanocytes, while a freckle (ephelis) shows increased pigmentation but no increase in melanocytes. It is sometimes very difficult to tell the difference histologically, and many pathologists refer to all such lesions as lentigo. Subtypes include lentigo simplex and solar lentigo, and can be hard to distinguish from flat seborrhoeic keratoses. Link ta clinical description of brown marks and freckles.
The histological features of lentigines are:
The melanocytic naevus or mole has considerable clinical and histological variability. Subtypes include junctional, compound, intradermal, congenital, dysplastic, blue and halo naevi. The subtypes are determined by the site and type of the naevus cells in the skin, and there is some correlation with the age of the patient. While these subtypes are largely descriptive congenital and dysplastic naevi can provide prognostic information. Link ta clinical description of melanocytic naevi.
The histological features of melanocytic naevi are:
Intradermal naevus Superficial naevus cells Deep naevus cells

Malignant melanoma is a tumour with significant potential to metastasise. Clinical variations include superficial, lentigo maligna, nodular, acrolentiginous and amelanotic melanoma. Link ta clinical description of malignant melanoma.
Histological variants of melanoma roughly parallel the clinical variants, but there are some differences, which may lead to misunderstandings. Histological categorization is based on the appearance of the in-situ component of the lesion (i.e. the non-invasive element of the tumour in the epidermis).
Histological types of invasive melanoma are show in the table below.
| Superficial spreading melanoma (SSM) | This is the commonest type, characterised by tumour cells in nests and singly spreading through all levels of the epidermis (Pagetoid spread). When present, the invasive dermal component usually consists of expansile nodules of cells which may be epithelioid, spindle or naevoid in type. In situ changes usually spread for some distance to the side of the invasive component. |
| Nodular melanoma | This is the second commonest tumour. Unlike SSM, there is no spread of intraepidermal tumour around the invasive component, which makes up almost the entire lesion. There is usually some tumour in the epithelium directly overlying the mass, but this may be mild, focal and hard to find. The tumour cells are typically large and epithelioid in type, but may be of spindle type. |
| Lentigo maligna melanoma (LMM) | This lesion often causes trouble with terminology. LMM arises within Hutchinson's Melanotic Freckle (also called lentigo maligna). The histology of the in-situ component is that of atypical single melanocytes along the basal layer of the epidermis and extending down adnexal glands. There is little Pagetoid spread and nesting is not marked in the early stages. The epidermis is typically thin and dermal solar elastosis marked. The invasive component shows no particular special features, but may be quite subtle on occasions and be accompanied by inflammation and melanophages (macrophages containing melanin). |
| Acral lentiginous melanoma | These arise on the palms, soles of the feet and the nail bed (subungual melanoma). They are relatively uncommon, but make up a significant proportion of melanomas that arise in dark skinned races. They show lentiginous proliferation of atypical melanocytes (which can be quite subtle) with some upwards single cell scatter. The dermal component is typically in the form of nodules. |
| Desmoplastic/ neurotropic melanoma | This is an uncommon variant of melanoma than is usually unsuspected prior to histology of a biopsy. Tumours typically arise on the head and neck and are composed of dermal spindle cells with associated fibrosis, often initially interpreted as scar tissue. The in situ component may be very subtle (often described as lentigo maligna). Tumour often invades nerves, and if this component is dominant, the lesion may be referred to as neurotropic melanoma. The perineural invasion may extend a considerable distance from the clinically apparent lesion, necessitating wide surgical margins for clearance. The tumour has a great tendency to recur locally, but evidence suggests that comparing tumours of a similar Breslow thickness, these lesions may have a slightly better prognosis as regards distant spread. |
The histological features of melanoma differ, depending on the type of tumour, but in general terms show:
Superficial spreading melanoma High power view Pathology of Superficial spreading melanoma Acrolentiginous melanoma High power view of pagetoid spread Pathology of melanoma Lentigo maligna Spindle cell tumour Pathology of melanoma

The prognosis of melanoma is very dependant on the stage at which the lesion is excised. Most lesions are confined to the primary site at presentation, but the prognosis of these can be stratified by microstaging, based upon the microscopic appearances. Two methods are generally employed, the Breslow thickness and the Clark levels. Both systems have their adherents, but the Breslow thickness has been found to be more reproducible between observers, and correlates more directly with prognosis.
Breslow thickness
Clark level
Other histological staging features
Tumour thickness in mm and the presence of ulceration are the two features required for staging the primary melanoma. Other features with prognostic significance that are also looked for in the melanoma include the degree of tumour infiltrating lymphocytes and the number of mitoses.
Benign and malignant tumours of inflammatory cells may involve the skin primarily or secondarily. The majority of these are lymphomas, which may be of T or B cell type. These tumours are uncommon, and only Mycosis Fungoides (a form of cutaneous T cell lymphoma- CTCL) will be described. Cutaneous T-cell lymphoma (CTCL) arises from the skin. Link to a clinical description of cutaneous T-cell lymphoma.
Mycosis fungoides is the most common form of CTCL and has several stages including patches, plaques and tumours. In early patch stage disease, it may not be possible to make a histological diagnosis of MF, and repeat biopsies as the disease progresses may be required, even when the clinical suspicion is strong.
The histological features of mycosis fungoides include:
The most common benign fibrous tissue lesion is the dermatofibroma (or benign fibrous histiocytoma), the exact nature of which is frequently debated. Link to a clinical description of dermatofibroma.
The histological features of dermatofibroma are:
This is a tumour that has conflicting clinical and histological features. Clinically, this is a tumour of the elderly arising in sun damaged skin. Histologically, there is severe nuclear atypia with many mitotic figures and features of a sarcoma located in the superficial and mid dermis.
The histological diagnosis is one of exclusion following immunohistochemistry, as spindle cell squamous carcinomas, melanomas and leiomyosarcomas may all appear similar. It is possible that this lesion's good prognosis is simply due tits superficial location, rather than its cell of origin, but the features are well recognised and the prognosis well documented so that its retention as a specific entity appears justified.

pathology of atypical fibroxanthoma
pathology of atypical fibroxanthoma

pathology of atypical fibroxanthoma
Examine a histopathology report of melanoma. What prognostic criteria are described? Refer to: Clinical Guidelines on the Management of Melanoma in Australia and New Zealand .
Information for patients
See the DermNet bookstore.